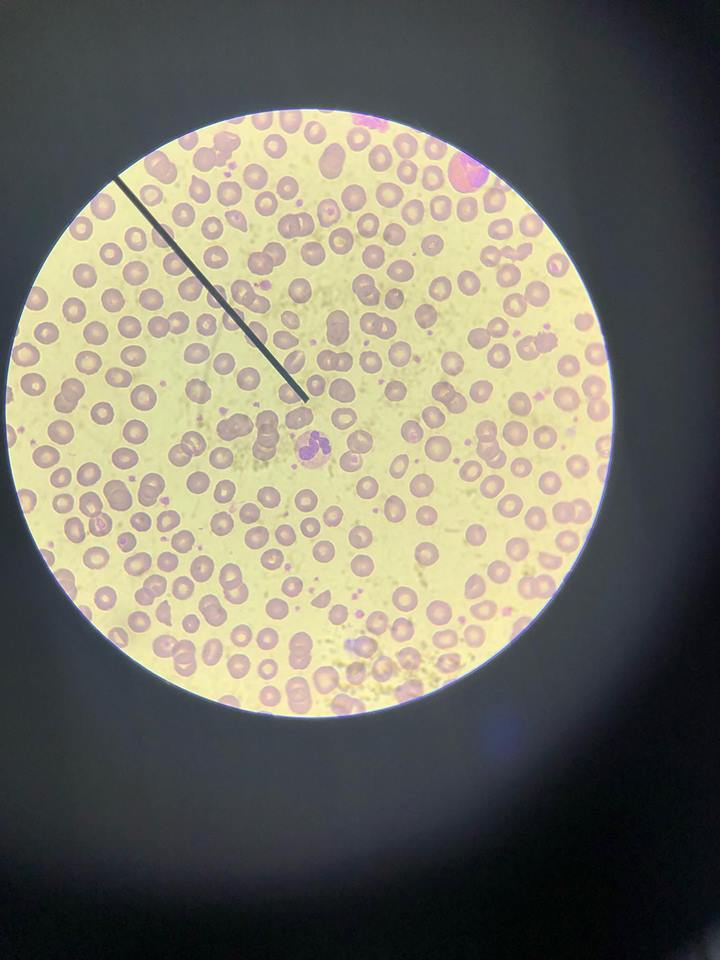
r52qv6tu2m.png

I remembered back when I was a child, I have always dreamed of becoming a healthcare provider - a doctor perhaps, analyzing patients' bodies, performing laboratory and paper works, diagnosing illnesses and taking good care of these patients. The little child's vivid array of dreams led me to pursue them since my attention was also caught up by the white coats that could be described as pristine and prestigious. Yet, this lifelong dream still brings me questions and doubts. Could this dream be fulfilled on its own perfect time, or is it just a phase in life where it will deliver me elsewhere instead?

Over the course of time as a first year pre-med student, I have learned a lot. "A lot" means completing three semesters of the academic term, studying 6 to 12 hours a day, and possibly damaging some brain cells. Pile after piles of lecture notes seemed forever to me and the feeling was quite challenging. Based on my experience, human anatomy and physiology was the most difficult subject to pass and phlebotomy was the most nerve-wracking. I've gotten to see a cadaver myself whilst inhaling the pungent smell of formalin. Additionally, my memory about 'George' was still fresh. George was named by my blockmates, frankly speaking he is a skeleton. I was not scared even a bit after seeing 'George' but what's creeping me out about him was that watching 'George' as he was casually displayed in every laboratory exam makes me wonder whether he suffered too much from these exams too and eventually just died becoming a skeleton, or not because he was carved out from wood. Somehow, laboratory exams and activities were very memorable for me because I managed to identify the different types of cute little creatures of white blood cells in the microsope.
After the sleepless nights of studying human anatomy and physiology (which seemed forever), I thought that it was the end of my suffering, but I was wrong and I realized that I was still at the starting point of my journey to these dreams of mine. Second semester came and phlebotomy was introduced too abrupt, too advanced for me, yet as what they always say: there is beauty in pain. True indeed. I saw myself as an epitome of beauty when I hit the right vein, and yes pain was as inevitable as seeing the discomfort displayed in the eyes of the patient.

Finally, I passed the first two semesters of the academic year and praise Jesus I did it. Afterwhich, summer semester embraced me with a brand new feeling. Why? Because my expectations led me to my misery thinking that summer would just be a piece of cake. Alas, it was quite a ride. Biochemistry could have possibly made it one hell of a ride during the semester, but I thanked God for sparing me for I just met the perfect example of an excellent instructor.

What I have learned so far were truly destined to be inculcated in the mind. I discovered that studying the human concept is as pulchritudinous as understanding the life prepared by God, the Creator. Grasping its complexities may seem arduous, but knowing that each step taken no matter how slow the progress, is still a progress. Thus, achieving these objectives in life no matter how small they are all interconnect to a one main goal - dream. And I believe I can make it - we can make it to our dream.
Congratulations
thank you!
I saw your brother @chuuuckie's tweet about this post, so I figured I'd come over and take a peek! 😊
What a great freewrite to start back with, @incredibleirah! Best of luck with your pre-med studies, and hope to see you here more often!
that's so kind of you! thank you 😍
You're very welcome, @incredibleirah! 💜 😊
Its good to have you back lil sis :O , thats a long free-write when I only advised you to make 50 words atleast at a minimum from this posts. But look at this lol, I know you are not busy these months and the next 2 months of this year. Enjoy again for another journey!
thankslol
Thanks for using eSteem!
Your post has been voted as a part of eSteem encouragement program. Keep up the good work! Install Android, iOS Mobile app or Windows, Mac, Linux Surfer app, if you haven't already!
Learn more: https://esteem.app
Join our discord: https://discord.gg/8eHupPq